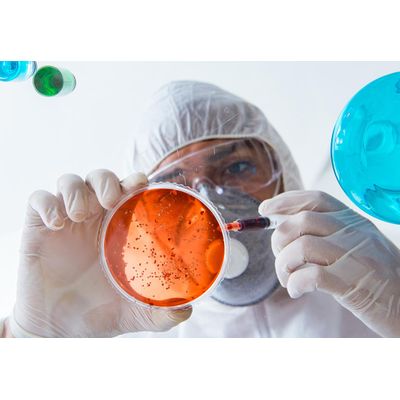

WHS - Water Hygiene Services
At Water Hygiene Systems we offer a simple testing and analysis service for small business, public organisations and major corporations.
Recent Health & Safety legislation has significantly increased the liability of plant operators. This is why registration to the newest BS EN ISO 9001 standard and the Legionella Control Association’s Code of Conduct for Service Providers is so important and will add an extra measurement of reassurance to all of those with whom we deal.
We offer a complete range of products and services for the industrial and commercial water treatment markets, from the largest cooling tower or steam boiler to the smallest domestic cold-water storage tank.
The services offered by Water Hygiene Systems Ltd are detailed as follows: –
Legionella Risk Assessment
Further to the publication of the recent code of practice from the Health & Safety Commission, we are able to offer a full water hygiene risk assessment of any given building to comply with the Health and Safety at Work etc. Act, the Control of Substances Hazardous to Health Regulations and the Health and Safety Commission’s Approved Code of Practice & Guidance (L8) document.
Bacteriological Analysis
A full range of analysis is offered from Legionella identification to a full bacteriological report detailing potable quality.
All samples will be analysed in accordance with recognised test methods and by independent UKAS accredited laboratories.
Bacteriological analysis can form part of a complete water hygiene programme and can also be used as a useful tool in fault identification processes.
Service
In accordance with our own Quality Management System, we place great emphasis on the service aspect of a water treatment programme. Regular service visits ensure that your plant is benefiting from the tailored water treatment programme, operating efficiently and receiving the correct application of treatment chemicals in the most economical manner.
On site analysis and monitoring of our water treatment programmes will be undertaken by fully trained representatives, using standard titration and colourmetric techniques.
A complete range of test kits for site use is available together with site training.
A detailed Cooling Tower Record File to conform to the requirements of the HSC Approved Code of Practice & Guidance (L8) document and the Environmental Health Office is available, which will ensure compliance with all Statutory Guidelines.
Site Services
Our water hygiene and chemical cleaning teams are fully equipped and experienced to offer a wide range of services including the following: –
- Cleaning and disinfection
- Pre-commission cleaning
- Chemical cleaning
- De-scaling
- Specialist paints and re-coatings
- Tank and pipework modifications or replacement
We take samples of water and residue from damp areas where potential bacteria and bugs, especially Legionella may be found which could lead to public health / disease outbreaks.

We analyse all the samples in our laboratory and report on the findings in full detail of the current and potential areas of concern or affect your regulatory requirements.

From the results, an action plan is produced which could be a one-off solution or a maintained operation to ensure high standards of water quality and health & safety regulations.

